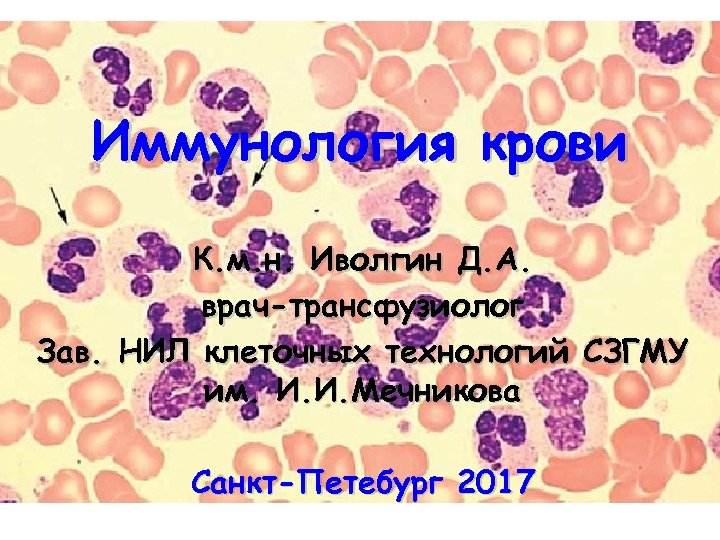

e124e20869711135291d010c00107f1c.ppt
- Количество слайдов: 34
Иммунология крови К. м. н. Иволгин Д. А. врач-трансфузиолог Зав. НИЛ клеточных технологий СЗГМУ им. И. И. Мечникова Санкт-Петебург 2017
Иммунология крови К. м. н. Иволгин Д. А. врач-трансфузиолог Зав. НИЛ клеточных технологий СЗГМУ им. И. И. Мечникова Санкт-Петебург 2017

 ЭПИГРАФ • «Переливание крови и её компонентов является пересадкой живой жидкой ткани, имеющий весьма сложный антигенный состав» Проф. , д. м. н. Дуткевич И. Г.
ЭПИГРАФ • «Переливание крови и её компонентов является пересадкой живой жидкой ткани, имеющий весьма сложный антигенный состав» Проф. , д. м. н. Дуткевич И. Г.
 ТЕРМИНОЛОГИЯ ИММУНОГЕМАТОЛОГИЯ – раздел иммунологии, гематологии и трансфузиологии, изучающий групповые антигены и групповые антитела крови человека, их значение в организме (в физиологии и при различных заболеваниях) и в трансфузиологической практике. Термин предложен французским ученым Ж. Доссе (J. Dausset) в 1956 г. ,
ТЕРМИНОЛОГИЯ ИММУНОГЕМАТОЛОГИЯ – раздел иммунологии, гематологии и трансфузиологии, изучающий групповые антигены и групповые антитела крови человека, их значение в организме (в физиологии и при различных заболеваниях) и в трансфузиологической практике. Термин предложен французским ученым Ж. Доссе (J. Dausset) в 1956 г. ,
 ОСНОВНЫЕ ЭТАПЫ ИСТОРИИ 1900 г. – Шатток в Америке (J. Pathol. a. Bacteriol. ) и К. Ландштейнер в Австрии (Centralbl. f. Bakteriol. ) впервые описали феномен изогемагглютинации, т. е. склеивание эритроцитов одного человека сывороткой крови другого человека вследствие взаимодействия антигенов и антител. 1901 г. – К. Ландштейнер впервые описал три группы крови у человека – А, В и С (по системе АВ 0) в зависимости от наличия в сыворотке крови одного или двух гемагглютининов (Wien. klin. Wschr. – 1901. – Jg. 14, N 46. –S. 1132 -1134).
ОСНОВНЫЕ ЭТАПЫ ИСТОРИИ 1900 г. – Шатток в Америке (J. Pathol. a. Bacteriol. ) и К. Ландштейнер в Австрии (Centralbl. f. Bakteriol. ) впервые описали феномен изогемагглютинации, т. е. склеивание эритроцитов одного человека сывороткой крови другого человека вследствие взаимодействия антигенов и антител. 1901 г. – К. Ландштейнер впервые описал три группы крови у человека – А, В и С (по системе АВ 0) в зависимости от наличия в сыворотке крови одного или двух гемагглютининов (Wien. klin. Wschr. – 1901. – Jg. 14, N 46. –S. 1132 -1134).
 ОСНОВНЫЕ ЭТАПЫ ИСТОРИИ 1902 г. – А. Декастелло и А. Штурли – сотрудники лаборатории К. Ландштейнера – описали четвертую группу крови (Munsch. med. Wschr. – 1902. – Jg. 49, N 26. – S. 1090 -1095), в сыворотке которой отсутствовали оба гемагглютинина. 1907 г. – чешский психиатр Я. Янский описал уже известные группы крови и предложил классификацию этих групп крови (I, III, IV). Ян Янский (1873– 1921)
ОСНОВНЫЕ ЭТАПЫ ИСТОРИИ 1902 г. – А. Декастелло и А. Штурли – сотрудники лаборатории К. Ландштейнера – описали четвертую группу крови (Munsch. med. Wschr. – 1902. – Jg. 49, N 26. – S. 1090 -1095), в сыворотке которой отсутствовали оба гемагглютинина. 1907 г. – чешский психиатр Я. Янский описал уже известные группы крови и предложил классификацию этих групп крови (I, III, IV). Ян Янский (1873– 1921)
 ОСНОВНЫЕ ЭТАПЫ ИСТОРИИ 1910 г. – В. Мосс в Америке описал уже известные четыре группы крови (обратная нумерация) и впервые приготовил типирующие гемагглютинирующие сыворотки для определения этих групп крови. 1910, 1911 гг. – Е. Дунгерн и Л. Хиршфельд предложили названия антигенов «А» и «В» , гемагглютининов - «альфа» и «бета» , а группы крови обозначать 0, А, В, АВ. 1928 г. - утверждена эта номенклатура групп крови по системе АВ 0 Конгрессом по судебной и социальной медицине
ОСНОВНЫЕ ЭТАПЫ ИСТОРИИ 1910 г. – В. Мосс в Америке описал уже известные четыре группы крови (обратная нумерация) и впервые приготовил типирующие гемагглютинирующие сыворотки для определения этих групп крови. 1910, 1911 гг. – Е. Дунгерн и Л. Хиршфельд предложили названия антигенов «А» и «В» , гемагглютининов - «альфа» и «бета» , а группы крови обозначать 0, А, В, АВ. 1928 г. - утверждена эта номенклатура групп крови по системе АВ 0 Конгрессом по судебной и социальной медицине
 ОСНОВНЫЕ ЭТАПЫ ИСТОРИИ 1927 г. – К. Ландштейнер и Ф. Левин в США обнаружили в эритроцитах антигены M и N (выделили три группы крови – М, N и MN). 1940 г. – К. Ландштейнер и А. Винер в США обнаружили новый эритроцитарный антиген, который назвали «Резус-фактор» , и выделили две группы крови – резус-положительную и резус-отрицательную 1953 г. – М. Стефанини (M. Stefanini) и Г. Плитман (G. Plitman) в США описали тромбоцитарные антигены. Филип Левин, 1900– 1987
ОСНОВНЫЕ ЭТАПЫ ИСТОРИИ 1927 г. – К. Ландштейнер и Ф. Левин в США обнаружили в эритроцитах антигены M и N (выделили три группы крови – М, N и MN). 1940 г. – К. Ландштейнер и А. Винер в США обнаружили новый эритроцитарный антиген, который назвали «Резус-фактор» , и выделили две группы крови – резус-положительную и резус-отрицательную 1953 г. – М. Стефанини (M. Stefanini) и Г. Плитман (G. Plitman) в США описали тромбоцитарные антигены. Филип Левин, 1900– 1987
 ОСНОВНЫЕ ЭТАПЫ ИСТОРИИ 1955 г. – О. Смитиес и Н. Ф. Валькер описали антигены плазменных белков – гаптоглобинов 1956 г. – Ж. Доссе описал лейкоцитарные антигены. Таким образом, все компоненты крови (клеточные и плазменные) человека имеют антигенные различия. К настоящему времени уже известно около 700 групповых антигенов крови, которые образуют около 75 антигенных систем.
ОСНОВНЫЕ ЭТАПЫ ИСТОРИИ 1955 г. – О. Смитиес и Н. Ф. Валькер описали антигены плазменных белков – гаптоглобинов 1956 г. – Ж. Доссе описал лейкоцитарные антигены. Таким образом, все компоненты крови (клеточные и плазменные) человека имеют антигенные различия. К настоящему времени уже известно около 700 групповых антигенов крови, которые образуют около 75 антигенных систем.
 ГРУППОВЫЕ АНТИГЕНЫ КРОВИ Групповые антигены крови – гликолипопротеины мембран клеток крови либо комплексы аминокислот или углеводов молекул плазменных белков, которые отличаются от других компонентов мембраны или белков двумя свойствами: 1) иммуногенностью, т. е. способностью индуцировать продукцию антител в организме, у которых эти групповые антигены отсутствуют; 2) серологической активностью (антигенной специфичностью) – способностью взаимодействовать (соединяться) с одноименными антителами.
ГРУППОВЫЕ АНТИГЕНЫ КРОВИ Групповые антигены крови – гликолипопротеины мембран клеток крови либо комплексы аминокислот или углеводов молекул плазменных белков, которые отличаются от других компонентов мембраны или белков двумя свойствами: 1) иммуногенностью, т. е. способностью индуцировать продукцию антител в организме, у которых эти групповые антигены отсутствуют; 2) серологической активностью (антигенной специфичностью) – способностью взаимодействовать (соединяться) с одноименными антителами.
 СТРУКТУРА ГРУППОВЫХ АНТИГЕНОВ КРОВИ гаптен –полисахарид, определяет серологическую активность шлеппер (иммуногенная молекула-носитель. ИМН) антигенные детерминанты (эпитопы) – углеводы, цепочки аминокислот
СТРУКТУРА ГРУППОВЫХ АНТИГЕНОВ КРОВИ гаптен –полисахарид, определяет серологическую активность шлеппер (иммуногенная молекула-носитель. ИМН) антигенные детерминанты (эпитопы) – углеводы, цепочки аминокислот
 ОСНОВНЫЕ АНТИГЕННЫЕ СИСТЕМЫ КРОВИ ЧЕЛОВЕКА ЭРИТРОЦИТАРНЫЕ АВ 0, RHESUS, KELL, KIDD, MNS, DUFFI, LEWIS, LUTHERAN, COLTON, CROMER, DIEGO, DOMBROCK, INDIAN, SCIANNA, P, Ii, Xg …. ЛЕЙКОЦИТАРНЫЕ AB 0 …. HLA (A, B, C, DR, DP, DQ); HNA (1 -5) СD (1 – 50) … ТРОМБОЦИТАРНЫЕ AB 0 … HLA, HPA (1 – 17) АНТИГЕНЫ ПЛАЗМЕННЫХ БЕЛКОВ (СЫВОРОТОЧНЫЕ) Альфа-глобулины - Hp, Gc, Pi …. Бета-глобулины – Tf, Bf …. Гамма-глобулины – Gm, Km, Am, Hv, Isf …. Липопротеины – Ag, Lp, Ld, Apo-E, El …. Комплемент – С 2, С 3, С 4, С 5 – С 8 ….
ОСНОВНЫЕ АНТИГЕННЫЕ СИСТЕМЫ КРОВИ ЧЕЛОВЕКА ЭРИТРОЦИТАРНЫЕ АВ 0, RHESUS, KELL, KIDD, MNS, DUFFI, LEWIS, LUTHERAN, COLTON, CROMER, DIEGO, DOMBROCK, INDIAN, SCIANNA, P, Ii, Xg …. ЛЕЙКОЦИТАРНЫЕ AB 0 …. HLA (A, B, C, DR, DP, DQ); HNA (1 -5) СD (1 – 50) … ТРОМБОЦИТАРНЫЕ AB 0 … HLA, HPA (1 – 17) АНТИГЕНЫ ПЛАЗМЕННЫХ БЕЛКОВ (СЫВОРОТОЧНЫЕ) Альфа-глобулины - Hp, Gc, Pi …. Бета-глобулины – Tf, Bf …. Гамма-глобулины – Gm, Km, Am, Hv, Isf …. Липопротеины – Ag, Lp, Ld, Apo-E, El …. Комплемент – С 2, С 3, С 4, С 5 – С 8 ….
 ИТАК: ГРУППА КРОВИ – это совокупность эритроцитарных, лейкоцитарных, тромбоцитарных и сывороточных (плазменных белков) антигенов, которая наследственно детерминирована и является постоянным индивидуальным биологическим свойством каждого человека. Группа крови, которая обычно определяется и выставляется в медицинских и других документах, учитывает только эритроцитарные антигены систем АВ 0, Резус и Келл поэтому не соответствует реальной группе крови индивидуума.
ИТАК: ГРУППА КРОВИ – это совокупность эритроцитарных, лейкоцитарных, тромбоцитарных и сывороточных (плазменных белков) антигенов, которая наследственно детерминирована и является постоянным индивидуальным биологическим свойством каждого человека. Группа крови, которая обычно определяется и выставляется в медицинских и других документах, учитывает только эритроцитарные антигены систем АВ 0, Резус и Келл поэтому не соответствует реальной группе крови индивидуума.
 ГРУППОВЫЕ АНТИТЕЛА КРОВИ – иммуноглобулины, направленные против групповых антигенов крови. Различают 5 классов иммуноглобулинов: Ig. M, Ig. G, Ig. A, Ig. D, Ig. E. Групповые антитела крови являются иммуноглобулинами Ig. M и Ig. G. Их молекулы состоят из тяжелых (Н) и легких (L) цепей аминокислот (полипептидных цепей). Ig. M появляются первыми при иммунизации, затем вместо них или одновременно с ними начинают синтезироваться Ig. G.
ГРУППОВЫЕ АНТИТЕЛА КРОВИ – иммуноглобулины, направленные против групповых антигенов крови. Различают 5 классов иммуноглобулинов: Ig. M, Ig. G, Ig. A, Ig. D, Ig. E. Групповые антитела крови являются иммуноглобулинами Ig. M и Ig. G. Их молекулы состоят из тяжелых (Н) и легких (L) цепей аминокислот (полипептидных цепей). Ig. M появляются первыми при иммунизации, затем вместо них или одновременно с ними начинают синтезироваться Ig. G.
 СХЕМАТИЧЕСКОЕ СТРОЕНИЕ ИММУНОГЛОБУЛИНОВ Паратопы Тяжелая цепь Легкая цепь
СХЕМАТИЧЕСКОЕ СТРОЕНИЕ ИММУНОГЛОБУЛИНОВ Паратопы Тяжелая цепь Легкая цепь
 МЕХАНИЗМЫ РЕАКЦИИ ВЗАИМОДЕЙСТВИЯ ГРУППОВЫХ АГ И АТ В реакции участвуют различные короткодействующие физические и химические силы, поэтому имеют значение расстояния между паратопами и соседними клетками крови с одноименными эпитопами. В реакции выделяют две фазы: 1) взаимодействия (фиксация антител на мембране клетки крови, снижение поверхностного отрицательного заряда клетки, сближение соседних клеток крови); 2) проявления (агглютинация клеток, цитолиз, преципитация).
МЕХАНИЗМЫ РЕАКЦИИ ВЗАИМОДЕЙСТВИЯ ГРУППОВЫХ АГ И АТ В реакции участвуют различные короткодействующие физические и химические силы, поэтому имеют значение расстояния между паратопами и соседними клетками крови с одноименными эпитопами. В реакции выделяют две фазы: 1) взаимодействия (фиксация антител на мембране клетки крови, снижение поверхностного отрицательного заряда клетки, сближение соседних клеток крови); 2) проявления (агглютинация клеток, цитолиз, преципитация).
 СХЕМА ПРЯМОЙ (АКТИВНОЙ) АГГЛЮТИНАЦИИ ЭРИТРОЦИТОВ ПРИ ВЗАИМОДЕЙСТВИИ С АНТИТЕЛАМИ Антитело Фаза взаимодействия Фаза проявления Эритроцит
СХЕМА ПРЯМОЙ (АКТИВНОЙ) АГГЛЮТИНАЦИИ ЭРИТРОЦИТОВ ПРИ ВЗАИМОДЕЙСТВИИ С АНТИТЕЛАМИ Антитело Фаза взаимодействия Фаза проявления Эритроцит
 СИСТЕМА АНТИГЕНОВ АВ 0 (система антигенов АВО и Нh – Донсков С. И. , Мороков В. А. , 2011) Антигены: Н, 0, А (А 1, А 2, А 3 …), В (В 1, В 2, В 3 …). имеются в мембране всех клеток крови, клетках эпителия, эндотелия и т. д. (гликосфинголипиды), в плазме крови, тканевых жидкостях (гликолипиды), секретах (слюне и др. ) организма (гликопротеины).
СИСТЕМА АНТИГЕНОВ АВ 0 (система антигенов АВО и Нh – Донсков С. И. , Мороков В. А. , 2011) Антигены: Н, 0, А (А 1, А 2, А 3 …), В (В 1, В 2, В 3 …). имеются в мембране всех клеток крови, клетках эпителия, эндотелия и т. д. (гликосфинголипиды), в плазме крови, тканевых жидкостях (гликолипиды), секретах (слюне и др. ) организма (гликопротеины).
 Агглютинин Агглютиноген Основой определения группы крови и резусфактора является реакция взаимодействия антигенантитело с последующим слипанием (агглютинацией) эритроцитов. Закон К. Ландштейнера: «В организме человека антиген группы крови (агглютиноген) и антитела к нему (агглютинины) никогда не сосуществуют» .
Агглютинин Агглютиноген Основой определения группы крови и резусфактора является реакция взаимодействия антигенантитело с последующим слипанием (агглютинацией) эритроцитов. Закон К. Ландштейнера: «В организме человека антиген группы крови (агглютиноген) и антитела к нему (агглютинины) никогда не сосуществуют» .
 ПОЛНЫЕ СЕРОЛОГИЧЕСКИЕ ФОРМУЛЫ ГРУПП КРОВИ ПО СИСТЕМЕ АВ 0: 0 анти-А, анти-В; А анти-В; В анти-А; АВ 0
ПОЛНЫЕ СЕРОЛОГИЧЕСКИЕ ФОРМУЛЫ ГРУПП КРОВИ ПО СИСТЕМЕ АВ 0: 0 анти-А, анти-В; А анти-В; В анти-А; АВ 0
 ПОЛНЫЕ СЕРОЛОГИЧЕСКИЕ ФОРМУЛЫ ГРУПП КРОВИ ПО СИСТЕМЕ АВ 0: 0 анти-А, анти-В; А анти-В; В анти-А; АВ 0 Группа Подгруппа Антигены Антитела Естественные экстрагглют инины Анти А Анти В O (I) A (II) A 1 A 2 Имунные Анти А Анти В - A 1 A 2 Анти В Анти А 1 B (III) B Анти А AB(IV) A 1 B A 2 B A 1 и B A 2 и B - Анти А 2 Анти А 1 -
ПОЛНЫЕ СЕРОЛОГИЧЕСКИЕ ФОРМУЛЫ ГРУПП КРОВИ ПО СИСТЕМЕ АВ 0: 0 анти-А, анти-В; А анти-В; В анти-А; АВ 0 Группа Подгруппа Антигены Антитела Естественные экстрагглют инины Анти А Анти В O (I) A (II) A 1 A 2 Имунные Анти А Анти В - A 1 A 2 Анти В Анти А 1 B (III) B Анти А AB(IV) A 1 B A 2 B A 1 и B A 2 и B - Анти А 2 Анти А 1 -

 Редкие и трудноопределяемые группы крови • Слабые варианты антигенов А и В • Гиперпластические группы крови (экстраагглютинины) • Кровяной химеризм (ТГСК, близнецы) • Дефективные группы крови (отсутствие естественного антитела анти-А или анти-В) • «Бомбейская» группа крови- отсутствие в эритроцитах всех антигенов системы АВ 0 (редкий генотип hh)
Редкие и трудноопределяемые группы крови • Слабые варианты антигенов А и В • Гиперпластические группы крови (экстраагглютинины) • Кровяной химеризм (ТГСК, близнецы) • Дефективные группы крови (отсутствие естественного антитела анти-А или анти-В) • «Бомбейская» группа крови- отсутствие в эритроцитах всех антигенов системы АВ 0 (редкий генотип hh)
 АНТИГЕННАЯ СИСТЕМА РЕЗУС Включает 88 антигенов и их вариантов (около 170 – Донсков С. И. , Мороков В. А. , 2011) Имеется 24 редко встречающихся антигенов (частота менее 1%), 8 часто встречающихся антигенов (частота более 99%, например Rh -total), частота остальных антигенов > 1% и < 90%. Наибольшее D, C, E, c, е, Cw. клиническое значение имеют антигены Имеется 4 номенклатуры обозначения антигенов системы Резус: А. Винера (1943) Р. Фишера и Р. Рейса (1946) Р. Розенфельда (1962) ISBT (Международного общества переливания крови) – 1990 г. Частота антигенов, % Rho D Rh 1 RH 1 85 rh’ rh” C E Rh 2 Rh 3 RH 2 RH 3 70 30 hr’ hr” c e Rh 4 Rh 5 RH 4 RH 5 80 98 rhw 1 Cw Rh 8 RH 8 2 –
АНТИГЕННАЯ СИСТЕМА РЕЗУС Включает 88 антигенов и их вариантов (около 170 – Донсков С. И. , Мороков В. А. , 2011) Имеется 24 редко встречающихся антигенов (частота менее 1%), 8 часто встречающихся антигенов (частота более 99%, например Rh -total), частота остальных антигенов > 1% и < 90%. Наибольшее D, C, E, c, е, Cw. клиническое значение имеют антигены Имеется 4 номенклатуры обозначения антигенов системы Резус: А. Винера (1943) Р. Фишера и Р. Рейса (1946) Р. Розенфельда (1962) ISBT (Международного общества переливания крови) – 1990 г. Частота антигенов, % Rho D Rh 1 RH 1 85 rh’ rh” C E Rh 2 Rh 3 RH 2 RH 3 70 30 hr’ hr” c e Rh 4 Rh 5 RH 4 RH 5 80 98 rhw 1 Cw Rh 8 RH 8 2 –

 Правило Оттенберга для подбора совместимой крови по системе АВ 0 0(I) A(II) B(III) AB(IV) B(III)
Правило Оттенберга для подбора совместимой крови по системе АВ 0 0(I) A(II) B(III) AB(IV) B(III)
 КЛИНИЧЕСКОЕ ЗНАЧЕНИЕ ГРУПП КРОВИ (в физиологии) 1. Групповые антигены крови – маркеры генотипа (от них зависит увеличение разнообразия генотипов человека, биологическая вариабельность клеточного состава крови, показателей белкового, углеводного, липидно- го и минерального обмена). 2. Лейкоцитарные антигены участвуют в обеспечении иммунологического гомеостаза. 3. Тромбоцитарные антигены участвуют в функционировании системы гемостаза. 4. Групповые антигены крови являются компонентами клеточной мембраны, поэтому от них зависит структурная прочность мембраны клеток крови (болезнь Rh null).
КЛИНИЧЕСКОЕ ЗНАЧЕНИЕ ГРУПП КРОВИ (в физиологии) 1. Групповые антигены крови – маркеры генотипа (от них зависит увеличение разнообразия генотипов человека, биологическая вариабельность клеточного состава крови, показателей белкового, углеводного, липидно- го и минерального обмена). 2. Лейкоцитарные антигены участвуют в обеспечении иммунологического гомеостаза. 3. Тромбоцитарные антигены участвуют в функционировании системы гемостаза. 4. Групповые антигены крови являются компонентами клеточной мембраны, поэтому от них зависит структурная прочность мембраны клеток крови (болезнь Rh null).
 КЛИНИЧЕСКОЕ ЗНАЧЕНИЕ ГРУПП КРОВИ (в физиологии) 5. Групповые антигены крови как компоненты клеточной мембраны участвуют в обеспечении трансмембранного транспорта различных веществ (воды, анионов, глицерина, мочевины). 6. Групповые антигены являются частью рецепторного аппарата клетки (обеспечивают высокую сорбционную способность эритроцитов, транспорт различных веществ, фиксацию на клетках патогенных агентов – бактерий, вирусов, простейших). 7. Групповые антигены (MNS, Gerbich) создают отрицательный заряд поверхности эритроцитов. 8. Антигены системы Cromer препятствуют фиксации к эритроцитам комплемента и предупреждают спонтанный гемолиз.
КЛИНИЧЕСКОЕ ЗНАЧЕНИЕ ГРУПП КРОВИ (в физиологии) 5. Групповые антигены крови как компоненты клеточной мембраны участвуют в обеспечении трансмембранного транспорта различных веществ (воды, анионов, глицерина, мочевины). 6. Групповые антигены являются частью рецепторного аппарата клетки (обеспечивают высокую сорбционную способность эритроцитов, транспорт различных веществ, фиксацию на клетках патогенных агентов – бактерий, вирусов, простейших). 7. Групповые антигены (MNS, Gerbich) создают отрицательный заряд поверхности эритроцитов. 8. Антигены системы Cromer препятствуют фиксации к эритроцитам комплемента и предупреждают спонтанный гемолиз.
 КЛИНИЧЕСКОЕ ЗНАЧЕНИЕ ГРУПП КРОВИ (в физиологии) 9. Групповые антигены и антитела выполняют защитные функции (антигены А и В в слюне, желудочном соке связывают фитогемолизины и фитоагглютинины, в семенной жидкости – обеспечивают жизнеспособность сперматозоидов в половых путях женщины; групповые антитела анти-А и анти-В связывают экзогенные антигены А и В и уменьшают вероятность иммунизации этими антигенами, а при несовместимости супругов по системе АВ 0 групповые антитела значительно уменьшают вероятность иммунологического конфликта при резуснесовместимой беременности).
КЛИНИЧЕСКОЕ ЗНАЧЕНИЕ ГРУПП КРОВИ (в физиологии) 9. Групповые антигены и антитела выполняют защитные функции (антигены А и В в слюне, желудочном соке связывают фитогемолизины и фитоагглютинины, в семенной жидкости – обеспечивают жизнеспособность сперматозоидов в половых путях женщины; групповые антитела анти-А и анти-В связывают экзогенные антигены А и В и уменьшают вероятность иммунизации этими антигенами, а при несовместимости супругов по системе АВ 0 групповые антитела значительно уменьшают вероятность иммунологического конфликта при резуснесовместимой беременности).
 КЛИНИЧЕСКОЕ ЗНАЧЕНИЕ ГРУПП КРОВИ (в патологии) От группы крови (чаще всего по лейкоцитарным антигенам) зависит: 1) вероятность (большая или меньшая) развития инфекционных и неинфекционных заболеваний; 2) характер течения заболевания (острое, хроническое); 3) распространенность патологического процесса; 4) возраст, в котором вероятнее всего разовьется неинфекционная патология; 5) результаты лечения.
КЛИНИЧЕСКОЕ ЗНАЧЕНИЕ ГРУПП КРОВИ (в патологии) От группы крови (чаще всего по лейкоцитарным антигенам) зависит: 1) вероятность (большая или меньшая) развития инфекционных и неинфекционных заболеваний; 2) характер течения заболевания (острое, хроническое); 3) распространенность патологического процесса; 4) возраст, в котором вероятнее всего разовьется неинфекционная патология; 5) результаты лечения.
 СВЯЗЬ ПОВЫШЕННОГО РИСКА ЗАБОЛЕВАНИЯ С ГРУППОВЫМИ АНТИГЕНАМИ КРОВИ (Туманов А. К. , Томилин В. В. , 1969; Зарецкая Ю. М. , 1983; Шабалин В. Н. , Серова Л. Д. , 1988; Зайцева Г. А. , 1999 и др. ) Заболевания Антигены крови Чума 0 Оспа А Туберкулез В, Rh(-), НLA-В 8 Вирусный гепатит HLA-B 18 (B 8, B 35, DR 3) Инфекционный эндокардит HLA-B 35 Язвенная болезнь 0 Бронхиальная астма 0 Rh(+) Гиперхолестеринемия, атеросклероз, ИБС, острый инфаркт миокарда (ОИМ), гипер. А тоническая болезнь, пернициозная анемия Злокачественные опухоли А, HLA-A 10, Bw 22 Хронический лимфолейкоз В Лейкозы (радиационные) HLA-Cw 3, Cw 4 Хронический миелолейкоз HLA-A 3, A 10, B 35
СВЯЗЬ ПОВЫШЕННОГО РИСКА ЗАБОЛЕВАНИЯ С ГРУППОВЫМИ АНТИГЕНАМИ КРОВИ (Туманов А. К. , Томилин В. В. , 1969; Зарецкая Ю. М. , 1983; Шабалин В. Н. , Серова Л. Д. , 1988; Зайцева Г. А. , 1999 и др. ) Заболевания Антигены крови Чума 0 Оспа А Туберкулез В, Rh(-), НLA-В 8 Вирусный гепатит HLA-B 18 (B 8, B 35, DR 3) Инфекционный эндокардит HLA-B 35 Язвенная болезнь 0 Бронхиальная астма 0 Rh(+) Гиперхолестеринемия, атеросклероз, ИБС, острый инфаркт миокарда (ОИМ), гипер. А тоническая болезнь, пернициозная анемия Злокачественные опухоли А, HLA-A 10, Bw 22 Хронический лимфолейкоз В Лейкозы (радиационные) HLA-Cw 3, Cw 4 Хронический миелолейкоз HLA-A 3, A 10, B 35
 СВЯЗЬ ПОВЫШЕННОГО РИСКА ЗАБОЛЕВАНИЯ С ГРУППОВЫМИ АНТИГЕНАМИ КРОВИ Миеломная болезнь (множественная В, HLA-B 17, Bw 22 миелома) Гломерулонефрит В Аутоиммунные заболевания HLA-A 1, B 8, DR 3 Заболевания суставов (ревматоидный артрит, синдром Рейтера, хронический анкилозирую. HLA-B 27 щий спондилоартрит) Псориаз HLA-Cw 6, B 13, B 17 Рассеянный склероз HLA-B 7, DR 2 Сахарный диабет инсулинзависимый A, HLA-B 18, B 35, DR 3, 4 -“-“-“-“-“- инсулиннезависимый А, HLA-B 8 Крупноочаговый ОИМ HLA-B 7, Cw 4 Мелкоочаговый ОИМ HLA-B 15 ИБС в возрасте до 30 лет HLA-B 7
СВЯЗЬ ПОВЫШЕННОГО РИСКА ЗАБОЛЕВАНИЯ С ГРУППОВЫМИ АНТИГЕНАМИ КРОВИ Миеломная болезнь (множественная В, HLA-B 17, Bw 22 миелома) Гломерулонефрит В Аутоиммунные заболевания HLA-A 1, B 8, DR 3 Заболевания суставов (ревматоидный артрит, синдром Рейтера, хронический анкилозирую. HLA-B 27 щий спондилоартрит) Псориаз HLA-Cw 6, B 13, B 17 Рассеянный склероз HLA-B 7, DR 2 Сахарный диабет инсулинзависимый A, HLA-B 18, B 35, DR 3, 4 -“-“-“-“-“- инсулиннезависимый А, HLA-B 8 Крупноочаговый ОИМ HLA-B 7, Cw 4 Мелкоочаговый ОИМ HLA-B 15 ИБС в возрасте до 30 лет HLA-B 7
 … the subject with which we have been dealing can also be developed by a study of the biological problem of individual serological differences in general, and in particular by the further improvement of techniques for the finer individual differentiation of human blood K. Landsteiner 1930 Nobel speech … предмет, которым мы занимаемся также может быть развиваться на основе изучения биологических проблем индивидуальных серологических различий в целом и, в частности, дальнейшее совершенствование технологий для более тонкой индивидуальной дифференцировки человеческой крови
… the subject with which we have been dealing can also be developed by a study of the biological problem of individual serological differences in general, and in particular by the further improvement of techniques for the finer individual differentiation of human blood K. Landsteiner 1930 Nobel speech … предмет, которым мы занимаемся также может быть развиваться на основе изучения биологических проблем индивидуальных серологических различий в целом и, в частности, дальнейшее совершенствование технологий для более тонкой индивидуальной дифференцировки человеческой крови
 Сделай двойную В-отрицательную СПАСИБО ЗА ВНИМАНИЕ
Сделай двойную В-отрицательную СПАСИБО ЗА ВНИМАНИЕ


